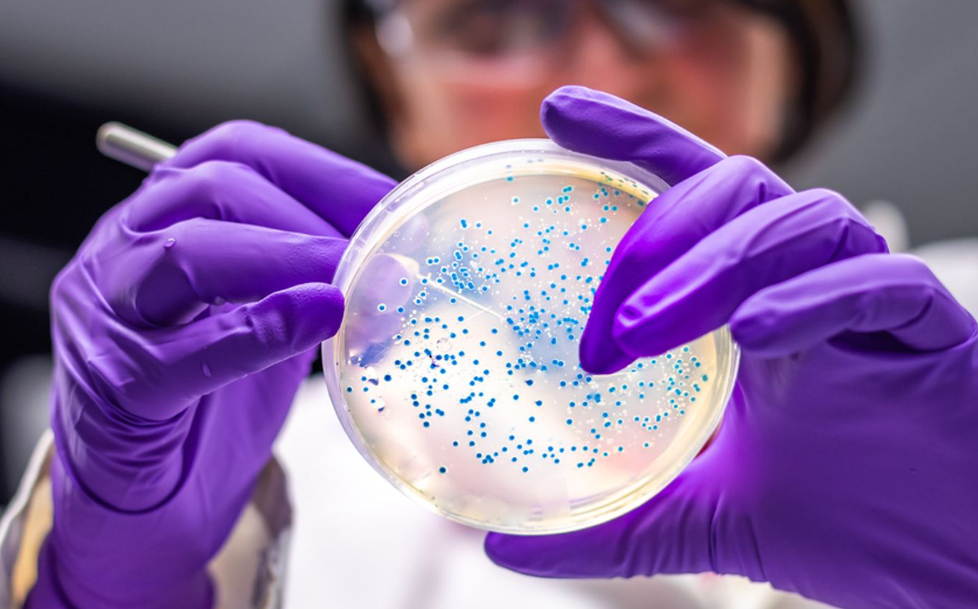

STEC is often transmitted by eating contaminated food but can also be spread by close contact with an infected person, as well as direct contact with an infected animal or where it lives.
Infections from a strain of E.coli that causes stomach issues rose by more than 25% last year - with toddlers most commonly affected, figures show.
The UK Health Security Agency has said the rise was partly down to a single outbreak linked to contaminated salad leaves, but also warned cases have been gradually increasing since 2022.